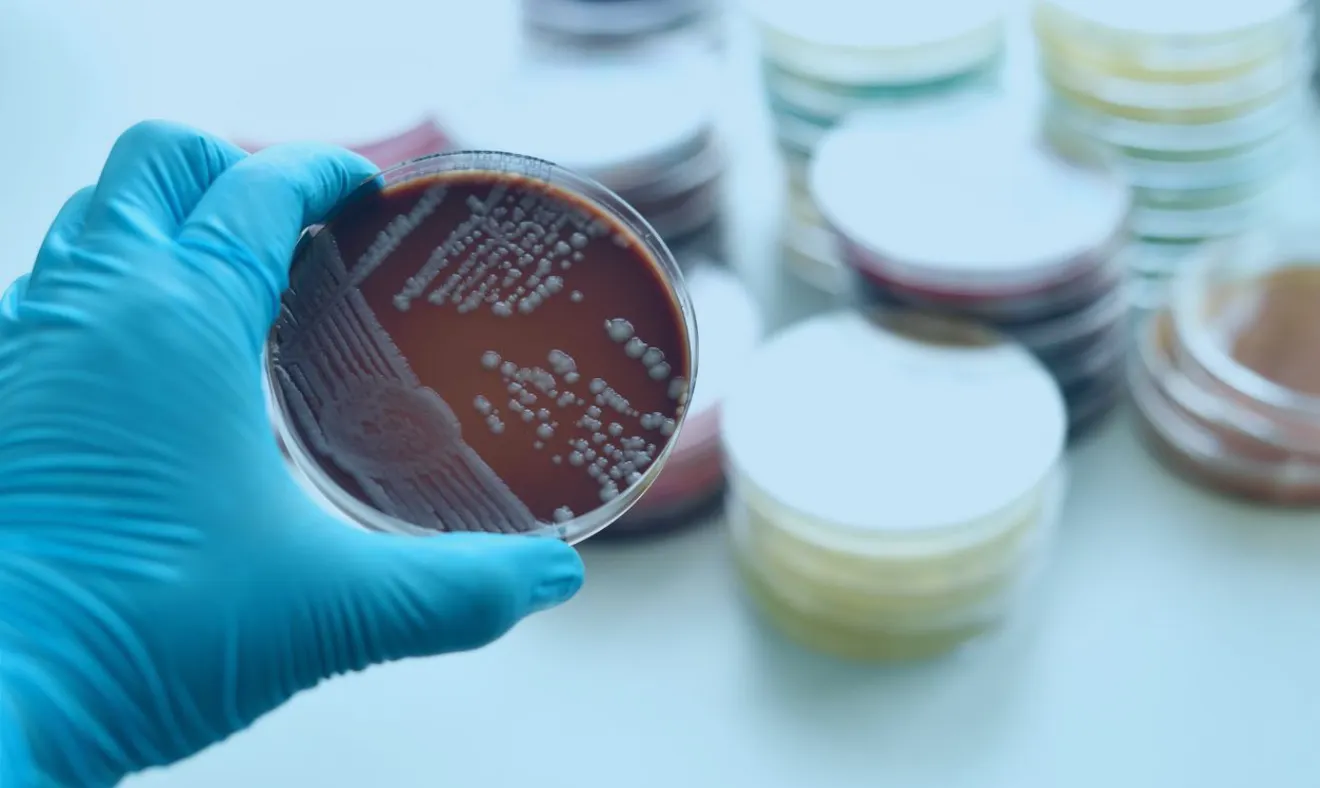
Neisseria gonorrhoeae: Como é feito e como funciona o preparo

Unidades em São Paulo
Exame Cultura Para Neisseria Gonorrhoeae
A cobertura varia conforme o convênio e plano, e deve ser verificada no momento do agendamento.
Não é necessário jejum.
17 Dias úteis
Apresentar documento de identificação oficial com foto (original ou cópia autenticada).
Seguindo as orientações dos órgãos de saúde, neste momento da pandemia será permitida a permanência de no máximo um acompanhante apenas nas seguintes situações: clientes idosos, menores de 18 anos, gestantes, pessoas com necessidades especiais ou para os exames que exigem a presença de acompanhante conforme o preparo enviado. Nos demais casos, não será permitida a presença de acompanhante.
Ficou com alguma dúvida?
O que é o exame CULTURA PARA NEISSERIA GONORRHOEAE e qual seu objetivo?
O exame CULTURA PARA NEISSERIA GONORRHOEAE é um método que tenta isolar a bactéria em laboratório a partir de amostra clínica. Ele ajuda a confirmar infecção por gonorreia. Também pode permitir avaliação de sensibilidade a antibióticos, dependendo do laboratório. O resultado depende muito da qualidade da coleta e transporte. A interpretação deve considerar sintomas e local da infecção.
Quando o exame CULTURA PARA NEISSERIA GONORRHOEAE é indicado?
O exame CULTURA PARA NEISSERIA GONORRHOEAE é indicado quando há suspeita clínica de gonorreia. Pode ser pedido em presença de corrimento, dor, ardor ao urinar ou cervicite/uretrite. Também pode ser útil em casos de falha terapêutica. A cultura é especialmente relevante quando se quer avaliar resistência antimicrobiana. A indicação final deve ser médica.
Qual tipo de amostra é usada no exame CULTURA PARA NEISSERIA GONORRHOEAE?
O exame CULTURA PARA NEISSERIA GONORRHOEAE pode usar swab de uretra, colo do útero, reto ou orofaringe, conforme exposição. A escolha do local depende dos sintomas e do histórico sexual. A coleta correta é decisiva para evitar falso negativo. O material deve ser enviado rapidamente ao laboratório. O procedimento deve ser feito por profissional treinado.
O exame CULTURA PARA NEISSERIA GONORRHOEAE é melhor do que testes moleculares?
O exame CULTURA PARA NEISSERIA GONORRHOEAE tem vantagens quando se deseja avaliar resistência a antibióticos. Já testes moleculares costumam ter alta sensibilidade e praticidade. A cultura pode falhar se o transporte não for adequado. Em alguns cenários, ambos podem ser usados de forma complementar. A escolha depende do objetivo clínico e disponibilidade local.
O exame CULTURA PARA NEISSERIA GONORRHOEAE pode ser usado para controle de cura?
O exame CULTURA PARA NEISSERIA GONORRHOEAE pode ser usado em situações selecionadas, como sintomas persistentes ou suspeita de resistência. O controle de cura depende do caso e das recomendações do serviço de saúde. Testar cedo demais após tratamento pode confundir interpretação. O acompanhamento deve incluir avaliação de parceiros e prevenção. A decisão deve ser individualizada pelo médico.
Agende ou compre seus exames de forma simples
- 1
Adicione seus procedimentos ao carrinho
Agendar seus exames online é rápido e fácil, trazendo conveniência e praticidade para o seu dia a dia.
- 2
Escolha o melhor dia e horário
Escolha o dia e hora que melhor se encaixe na sua rotina
- 3
Realize seus procedimentos
Faça seus procedimentos na unidade escolhida
- 4
Tenha acesso aos seus resultados sem sair de casa
Tenha acesso aos resultados dos seus exames onde e quando quiser. Conheça o Portal do Paciente.